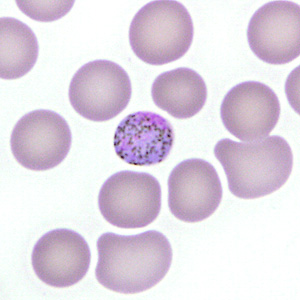
Case277_D.jpg

Case #277 – June, 2010
A 29-year-old female went to her health care provider with complaints of fever and headache, two weeks after returning home from trips to Uganda and Sudan. She admitted that she only took malaria prophylaxis whenever she did not feel well. A blood smear was ordered by her physician. Figures A–F show what was observed on a Giemsa-stained thin blood smear. What is your diagnosis? Based on what criteria?

Figure A

Figure B

Figure C
Figure D

Figure E

Figure F
Images presented in the DPDx case studies are from specimens submitted for diagnosis or archiving. On rare occasions, clinical histories given may be partly fictitious.
DPDx is an educational resource designed for health professionals and laboratory scientists. For an overview including prevention, control, and treatment visit www.cdc.gov/parasites/.